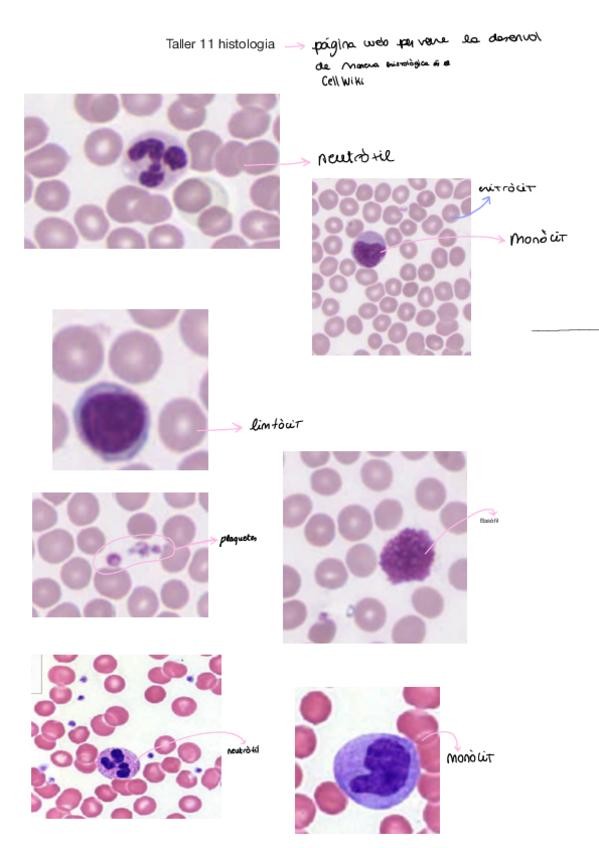

@inesdominguezzz
Estudios: Grado en Medicina (UVIC)
5 Publicaciones
24 Interacciones
0 Seguidores
2 Siguiendo
Lista de publicaciones de inesdominguezzz
He publicado nuevos practicas de 1º Estructura i Funció del Cos Humà II: Taller-Histo-20.pdf
He publicado nuevos practicas de 1º Estructura i Funció del Cos Humà II: Taller.pdf
He publicado nuevos practicas de 1º Estructura i Funció del Cos Humà II: T21-Depuracio-renal-2.pdf
He publicado nuevos practicas de 1º Estructura i Funció del Cos Humà II: TLL18-ANAT-SIST-RENAL-URIN-25-26-Dr.-Sanchez-Martin.pdf
He publicado nuevos practicas de 1º Estructura i Funció del Cos Humà II: Taller-diuretics-25-26Estudiants-1.pdf